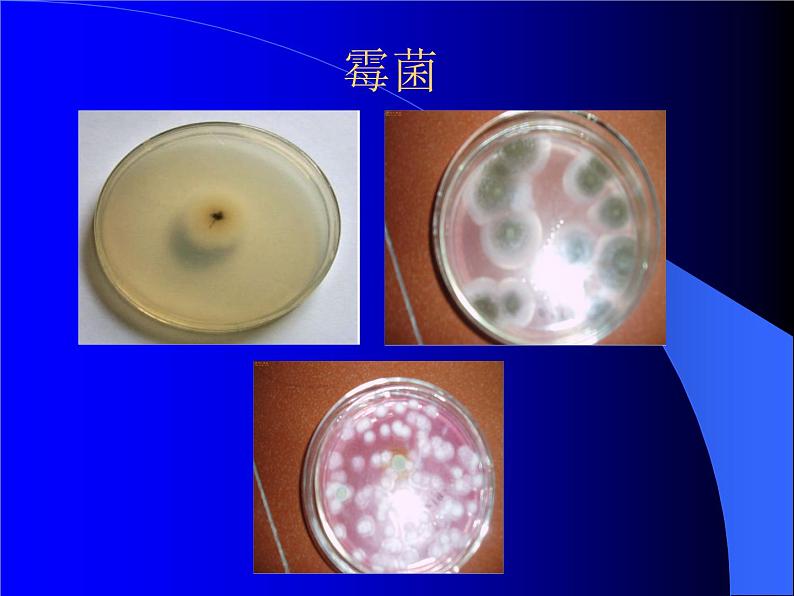

初中生物北师大版七年级上册第2节 生物与环境的相互影响课文内容课件ppt
展开金鱼、仙人掌分别生活在什么环境中?如果把它们的生活环境对调,结果会怎么?这说明了什么问题?
答:这说明了环境影响生物的生存。
(光、水、温度、空气、土壤等)
(影响某种生物生活的其他生物。)
何为生态因素、生物因素和非生物因素?
(环境中影响生物形态、生理、分布的各种因素称为生态因素。)
观察下列生物现象,说明生物受何种因素的影响?
活动:探究温度对霉菌生活的影响
2、该实验说明了什么问题?
1、根据你的日常观察和经验,你认为选用哪种食品容易长出霉菌?
答:面包、馒头等湿润、营养物质丰富的食品。
答:霉菌适于生活在温暖的环境里。
答:生物不仅受非生物因素的影响,还受生物因素的影响。
观察课本第16页图片及下面的图片,说明了什么问题?
讨论:你能从日常生活中找到生物适应环境的例子吗?
(例:仙人球适于生活干旱的环境。)
退化成刺,可以减少水的散失
非常发达,吸收深处水分。
绿色肥厚,储存大量的水,且代替叶进行光合作用。
讨论: 蚯蚓对它生活的环境有哪些影响?
活动: 测量不同植被环境的空气温度和湿度
如果适度大,相差达,如果干燥,相差小 原理:两温度计中干泡温度计玻璃泡暴露在空气中,显示的是空气的温度即室温;湿泡温度计的玻璃泡被湿布包起来,因湿布中水分蒸发吸热,所以湿泡温度计示数小于干泡温度计示数。并且当天空气越干燥,蒸发越快,吸热越多,两温度计示数差越大;反之空气中水蒸气越多即湿度越大时,蒸发越慢,两温度计的示数差越小,所以两温度计的示数差能反映空气中水蒸气的含量。
例如,设干泡温度计所示的温度是22℃,湿泡温度计所指示的是16℃,两泡的温度差是6℃,可先在表中所示温度一行找到22℃,又在温度一行找到6℃,再把22℃横向与6℃竖行对齐,找到数值54。它的意思就是相对湿度是54%
1、绿色植物对环境能起到什么作用?
答:绿色植物对环境起着降低温度和增大湿度的作用。
2、通过本节课的学习,你有什么心 得体会?
答:我们要提倡植树造林和绿化大地,创建适合人们生活的环境。
3、小组讨论:生物对环境造成不利影响的实例。
随堂练习: 1、生态因素包括__和__。 2、非生物因素包括___、___ 、__ 、__等多种因素,你能说出生活中生物受非生物因素影响的例子吗? 3、生物因素是指______,它包括___和___的相互影响,你能举出一些例子吗? 4、在一个繁殖季节里,一条鲤鱼能产几十万粒卵,而一般的小型鸟类只产几个卵,你能说出其中的道理吗?这是不是生物对环境的适应?
初中生物北师大版七年级上册第一单元 认识生命第1章 生命的世界第2节 生物与环境的相互影响优秀ppt课件: 这是一份初中生物北师大版七年级上册第一单元 认识生命第1章 生命的世界第2节 生物与环境的相互影响优秀ppt课件,共26页。PPT课件主要包含了情境导入,生物与环境的关系,环境对生物的影响,生态因素,非生物因素,生物因素,向日葵,春江水暖鸭先知,蒲公英撒播种子,仙人掌的叶退化成刺等内容,欢迎下载使用。
初中生物北师大版七年级上册第2节 生物与环境的相互影响获奖课件ppt: 这是一份初中生物北师大版七年级上册第2节 生物与环境的相互影响获奖课件ppt,共45页。
北师大版七年级上册第2节 生物与环境的相互影响教学演示ppt课件: 这是一份北师大版七年级上册第2节 生物与环境的相互影响教学演示ppt课件,文件包含第2节生物与环境的相互影响pptx、第2节生物与环境的相互影响docx等2份课件配套教学资源,其中PPT共24页, 欢迎下载使用。